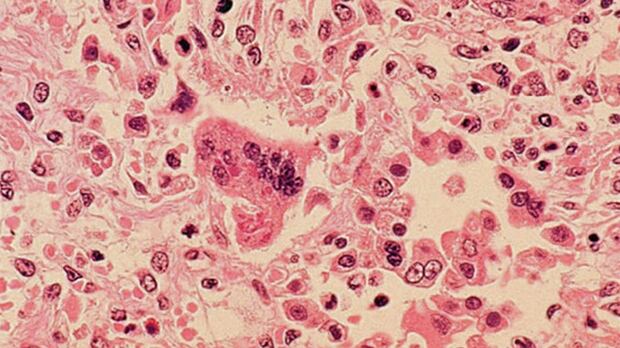

11-month-old girl who recently travelled to India first MB measles patient of 2015
Published:
Here Are The 60 Best Advent Calendars For 2025 You Can Get In Canada (So Far)
I’ve been Using This Canadian Shampoo And Conditioner For Over A Month, And It’s Totally Changed My Scalp And Hair Health
20 Foolproof Gifts To Order If You Want To Get Your Holiday Shopping Done Early
I Tried It: A Laundry Basket So Smart It Solved Our Biggest Household Argument
20 Things From Amazon Canada That CTV Shopping Trends Readers Loved Ordering In October
How To Choose The Best Vacuum Sealer For You (And A Few Of Our Favourite Models For 2025)
13 Budget-Friendly Beauty Products That Are Dupes Of More Expensive Items
12 Products For Damaged Hair That’ll Help Bring Your Fried Tresses Back To Life
15 Of The Best Korean Beauty Skincare Finds For Fall 2025
27 Of The Absolute Best Last-Minute Beauty Discounts To Take Advantage Of Before The Amazon Prime Big Deal Days Sale Ends
The Shopping Trends team is independent of the journalists at CTV News. We may earn a commission when you use our links to shop. Read about us.





































































